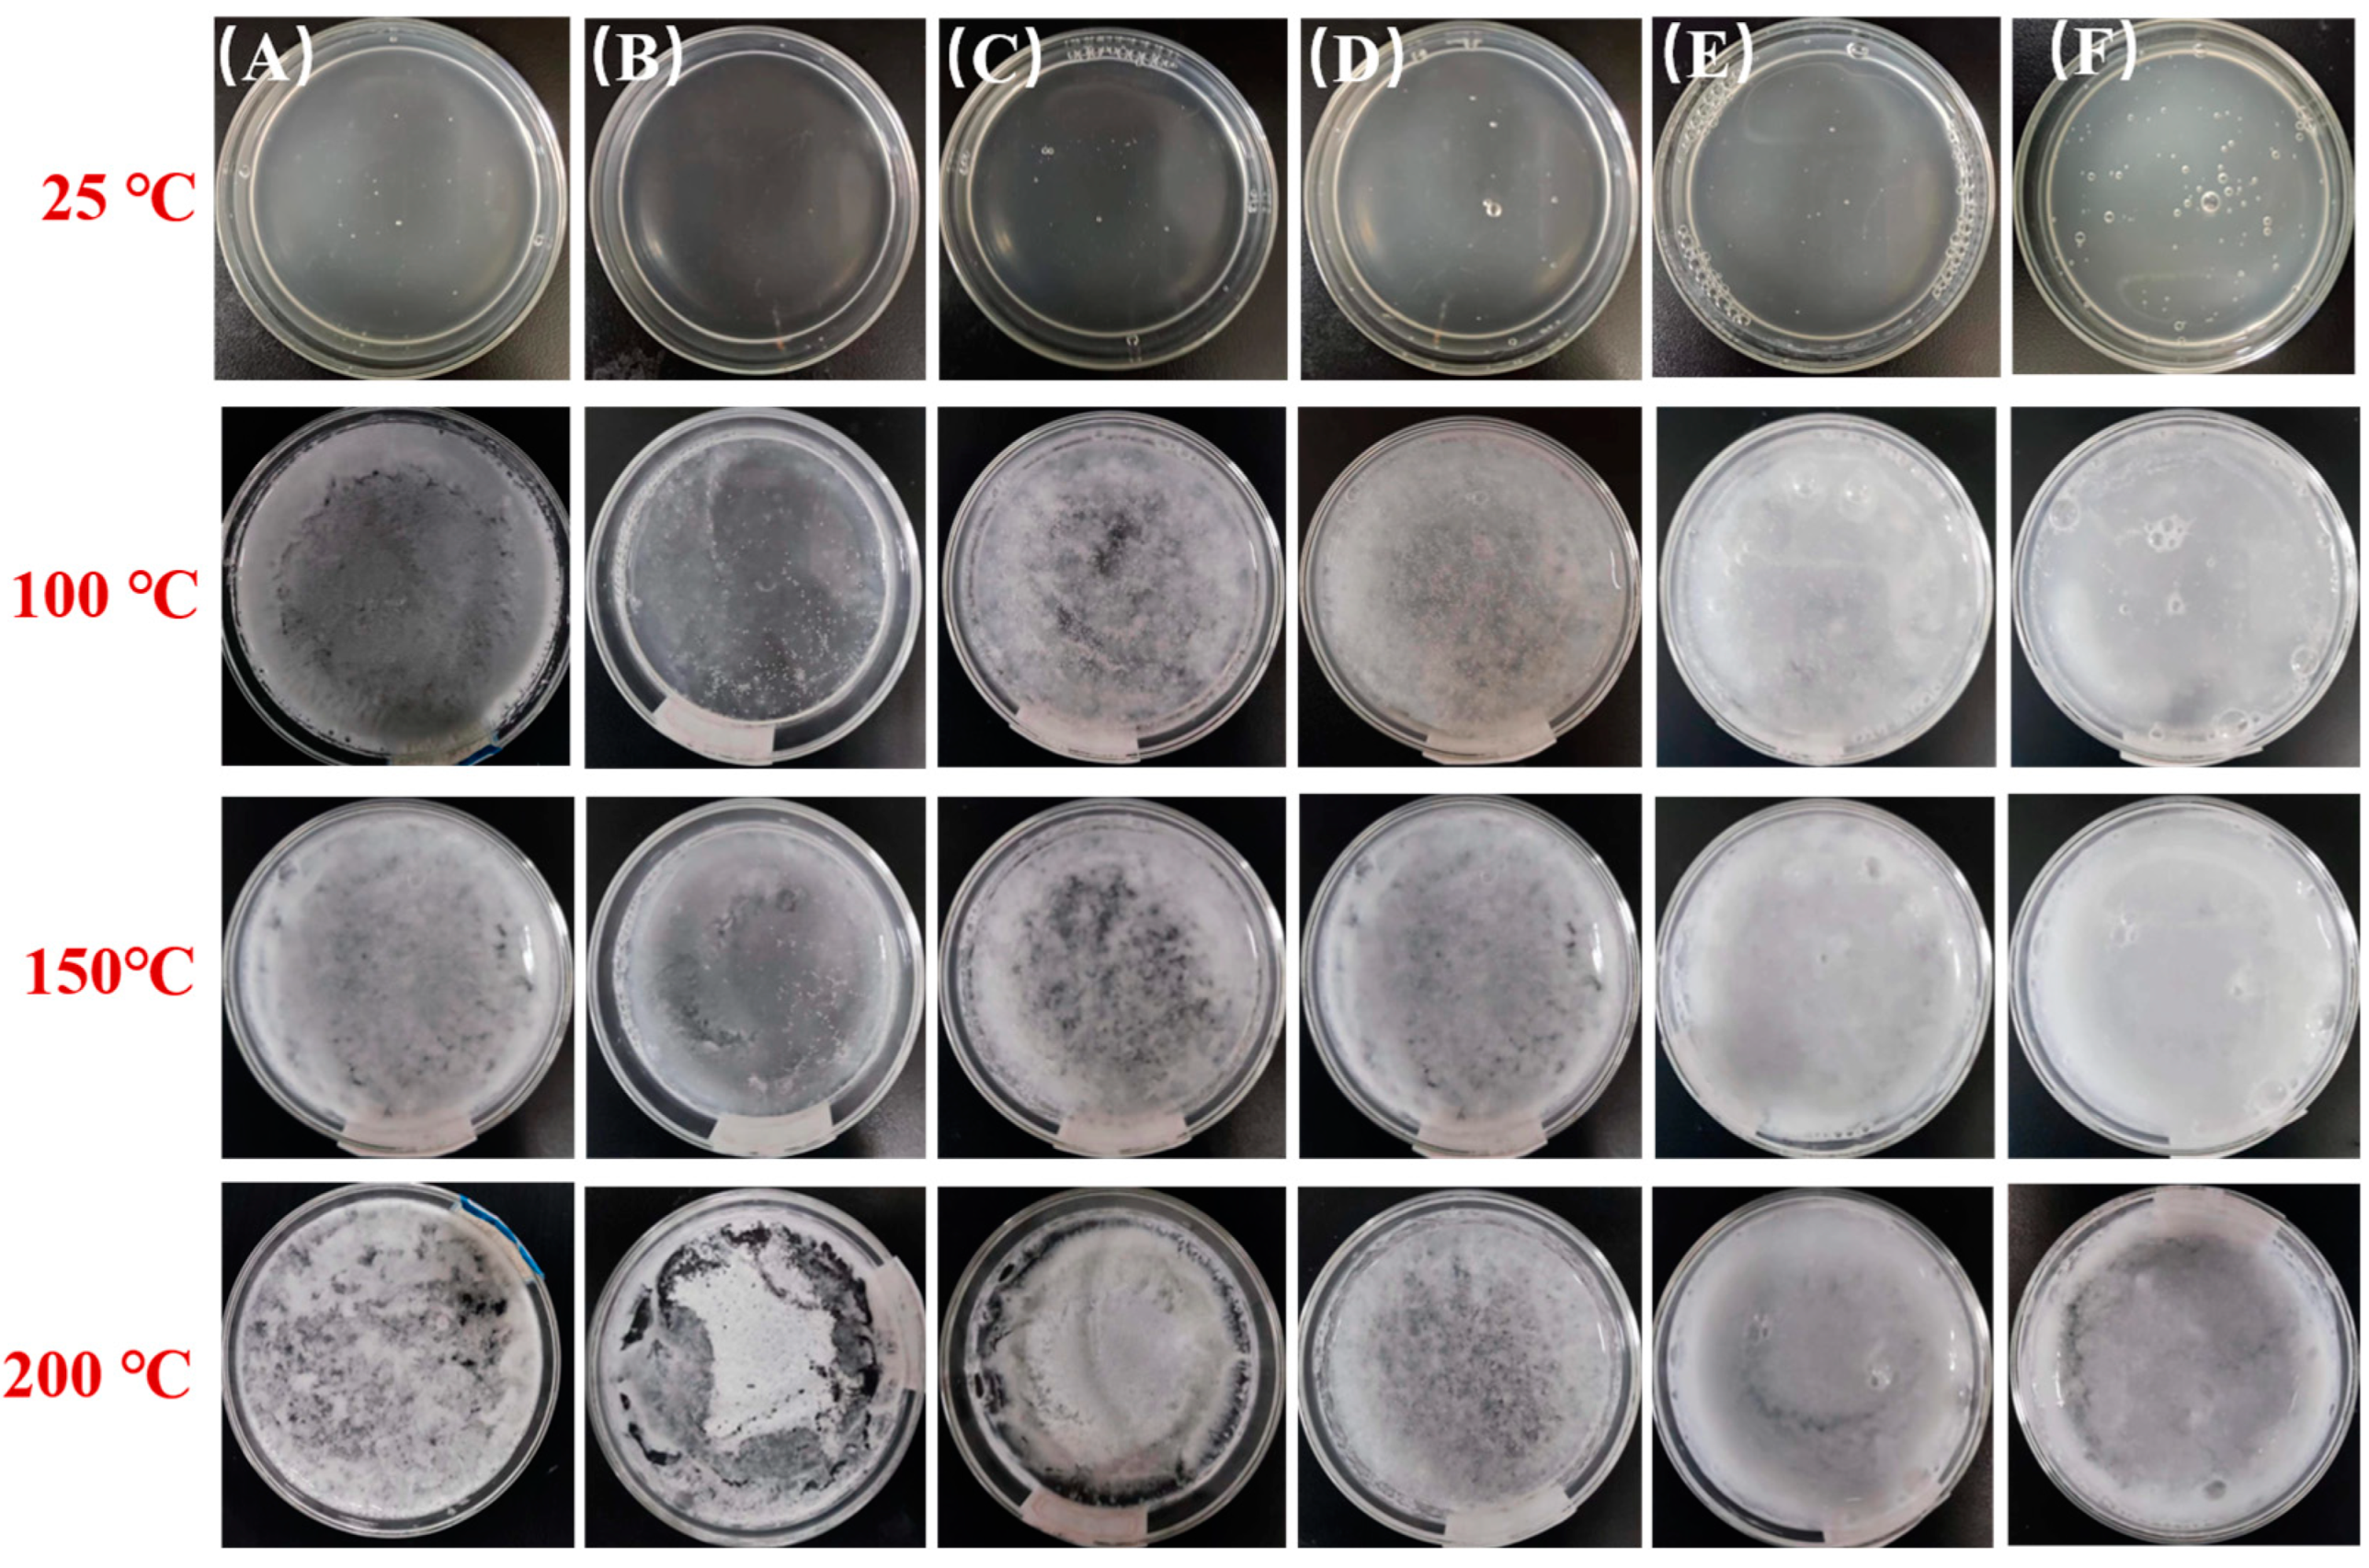
Gels 09 00667 g003

Wettability of HPMC/PEG/CS Thermosensitive Porous Hydrogels
Abstract
:1. Introduction
2. Results and Discussion
2.1. Basic Properties of the HPC Porous Systems
2.2. Spreadability of the HPC Porous Systems on the Wood Surface
2.2.1. Spreading Behavior of the Aqueous Pre-Gel Droplets
2.2.2. Spreading Coefficient of the Aqueous Pre-Gel Systems
2.3. Adhesivity of the HPC Porous Hydrogels on the Wood Surface
2.3.1. The Adhesive Force of the Aqueous Pre-Gel Droplets
2.3.2. Adhesivity of the Gels after the Phase Transition
2.4. Wettability of the HPC Systems
2.4.1. The Surface-Free Energy of the Wood Surface Wetted by the Aqueous Pre-Gel Droplets
2.4.2. Wettability of the Gels after the Phase Transition
3. Conclusions
4. Materials and Methods
4.1. Materials
4.2. Synthesis of HPMC/PEG/CS Thermosensitive Porous Hydrogel Concentrate
4.3. Equipments and Procedures
4.3.1. Testing the Basic Properties of the HPC Porous Systems
4.3.2. Adhesion Weight Ratio Measurements
Author Contributions
Funding
Institutional Review Board Statement
Informed Consent Statement
Data Availability Statement
Conflicts of Interest
References
- Huang, Y.; Wencheng, Z.; Dai, X.; Zhao, Y. Study on water-based fire extinguishing agent formulations and properties. Procedia Eng. 2012, 45, 649–654. [Google Scholar] [CrossRef]
- Sheng, Y.; Peng, Y.; Zhang, S.; Guo, Y.; Ma, L.; Wang, Q.; Zhang, H. Study on thermal stability of gel foam co-stabilized by hydrophilic silica nanoparticles and surfactants. Gels 2022, 8, 123. [Google Scholar] [CrossRef]
- Sheng, Y.; Yan, C.; Li, Y.; Guo, Y.; Ma, L.; Peng, Y. Thermal stability of gel foams co-stabilized by nano-aluminum hydroxide and surfactants. J. Sol-Gel Sci. Technol. 2022, 105, 127–138. [Google Scholar] [CrossRef]
- Li, Y.; Hu, X.; Cheng, W.; Shao, Z.; Xue, D.; Zhao, Y.; Lu, W. A novel high-toughness, organic/inorganic double-network fire-retardant gel for coal-seam with high ground temperature. Fuel 2020, 263, 116779. [Google Scholar] [CrossRef]
- Xu, H.; Xu, P.; Wang, D.; Yang, Y.; Wang, X.; Wang, T.; An, W.; Xu, S.; Wang, Y.-Z. A dimensional stable hydrogel-born foam with enhanced mechanical and thermal insulation and fire-retarding properties via fast microwave foaming. Chem. Eng. J. 2020, 399, 125781. [Google Scholar] [CrossRef]
- Zhou, G.; Li, S.; Meng, Q.; Tian, F.; Sun, L. Synthesis and performance of a new temperature-sensitive and super-absorbent fire prevention hydrogel based on ultrasonic method. Colloids Surfaces A Physicochem. Eng. Asp. 2022, 640, 128399. [Google Scholar] [CrossRef]
- Cheng, W.; Hu, X.; Xie, J.; Zhao, Y. An intelligent gel designed to control the spontaneous combustion of coal: Fire prevention and extinguishing properties. Fuel 2017, 210, 826–835. [Google Scholar] [CrossRef]
- Yu, Y.; Cheng, Y.; Tong, J.; Zhang, L.; Wei, Y.; Tian, M. Recent advances in thermo-sensitive hydrogels for drug delivery. J. Mater. Chem. B 2021, 9, 2979–2992. [Google Scholar] [CrossRef] [PubMed]
- Tsai, Y.-T.; Yang, Y.; Wang, C.; Shu, C.-M.; Deng, J. Comparison of the inhibition mechanisms of five types of inhibitors on spontaneous coal combustion. Int. J. Energy Res. 2017, 42, 1158–1171. [Google Scholar] [CrossRef]
- Jiang, Z.; Dou, G. Preparation and Characterization of Chitosan Grafting Hydrogel for Mine-Fire Fighting. ACS Omega 2020, 5, 2303–2309. [Google Scholar] [CrossRef] [PubMed]
- Dezotti, R.S.; Furtado, L.M.; Yee, M.; Valera, T.S.; Balaji, K.; Ando, R.A.; Petri, D.F.S. Tuning the mechanical and thermal properties of hydroxypropyl methylcellulose cryogels with the aid of surfactants. Gels 2021, 7, 118. [Google Scholar] [CrossRef] [PubMed]
- Kareem, S.A.; Dere, I.; Gungula, D.T.; Andrew, F.P.; Saddiq, A.M.; Adebayo, E.F.; Tame, V.T.; Kefas, H.M.; Joseph, J.; Patrick, D.O. Synthesis and characterization of slow-release fertilizer hydrogel based on hydroxy propyl methyl cellulose, polyvinyl alcohol, glycerol and blended paper. Gels 2021, 7, 262. [Google Scholar] [CrossRef] [PubMed]
- Nigmatullin, R.; Gabrielli, V.; Muñoz-García, J.C.; Lewandowska, A.E.; Harniman, R.; Khimyak, Y.Z.; Angulo, J.; Eichhorn, S.J. Thermosensitive supramolecular and colloidal hydrogels via self-assembly modulated by hydrophobized cellulose nanocrystals. Cellulose 2019, 26, 529–542. [Google Scholar] [CrossRef]
- Vassiliadi, E.; Tsirigotis-Maniecka, M.; Symons, H.E.; Gobbo, P.; Nallet, F.; Xenakis, A.; Zoumpanioti, M. (Hydroxypropyl)methyl cellulose-chitosan film as a matrix for lipase immobilization—Part II: Structural studies. Gels 2022, 8, 595. [Google Scholar] [CrossRef] [PubMed]
- Li, B.; Zhang, L.; Wang, D.; Liu, X.; Li, H.; Liang, C.; Zhao, X. Thermo-sensitive hydrogel on anodized titanium surface to regulate immune response. Surf. Coat. Technol. 2020, 405, 126624. [Google Scholar] [CrossRef]
- Wang, T.; Chen, L.; Shen, T.; Wu, D. Preparation and properties of a novel thermo-sensitive hydrogel based on chitosan/hydroxypropyl methylcellulose/glycerol. Int. J. Biol. Macromol. 2016, 93, 775–782. [Google Scholar] [CrossRef]
- Hu, M.; Yang, J.; Xu, J. Structural and biological investigation of chitosan/hyaluronic acid with silanized-hydroxypropyl methylcellulose as an injectable reinforced interpenetrating network hydrogel for cartilage tissue engineering. Drug Deliv. 2021, 28, 607–619. [Google Scholar] [CrossRef]
- Chang, H.; Meng, L.; Shao, C.; Cui, C.; Yang, J. Physically cross-linked silk hydrogels with high solid content and excellent mechanical properties via a reverse dialysis concentrated procedure. ACS Sustain. Chem. Eng. 2019, 7, 13324–13332. [Google Scholar] [CrossRef]
- Lu, H.; Ren, S.; Li, X.; Guo, J.; Dong, G.; Li, J.; Gao, L. Poly(ethylene glycol)/chitosan/sodium glycerophosphate gel replaced the joint capsule with slow-release lubricant after joint surgery. J. Biomater. Sci. Polym. Ed. 2018, 29, 1331–1343. [Google Scholar] [CrossRef]
- Kim, S.; Choi, H. Switchable wettability of thermoresponsive core–shell nanofibers for water capture and release. ACS Sustain. Chem. Eng. 2019, 7, 19870–19879. [Google Scholar] [CrossRef]
- Ma, L.; Huang, X.; Sheng, Y.; Liu, X.; Wei, G. Experimental study on thermosensitive hydrogel used to extinguish class A fire. Polymers 2021, 13, 367. [Google Scholar] [CrossRef] [PubMed]
- Butler, M.D.; Montenegro-Johnson, T.D. The swelling and shrinking of spherical thermo-responsive hydrogels. J. Fluid Mech. 2022, 947, A11. [Google Scholar] [CrossRef]
- Li, Y.; Sun, S.; Gao, P.; Zhang, M.; Fan, C.; Lu, Q.; Li, C.; Chen, C.; Lin, B.; Jiang, Y. A tough chitosan-alginate porous hydrogel prepared by simple foaming method. J. Solid State Chem. 2020, 294, 121797. [Google Scholar] [CrossRef]
- Zhang, Y.; Gao, P.; Zhao, L.; Chen, Y. Preparation and swelling properties of a starch-g-poly(acrylic acid)/organo-mordenite hydrogel composite. Front. Chem. Sci. Eng. 2015, 10, 147–161. [Google Scholar] [CrossRef]
- Zhang, T.; Xu, Z.; Gui, H.; Guo, Q. Emulsion-templated, macroporous hydrogels for enhancing water efficiency in fighting fires. J. Mater. Chem. A 2017, 5, 10161–10164. [Google Scholar] [CrossRef]
- Xiao, G.; Li, F.; Li, Y.; Chen, C.; Chen, C.; Liu, Q.; Chen, W. A novel biomass material composite hydrogel based on sodium alginate. Colloids Surfaces A Physicochem. Eng. Asp. 2022, 648, 129383. [Google Scholar] [CrossRef]
- Yang, Y.; Zhu, H.; Tsai, Y.-T.; Bai, L.; Deng, J. Study on the thermal stability of thermosensitive hydrogel. Procedia Eng. 2016, 135, 501–509. [Google Scholar] [CrossRef]
- Ma, L.; Shi, T.; Liu, X.; Wang, X.; Zhang, X. Structural properties of HPMC/PEG/CS thermosensitive porous hydrogels. Polym. Bull. 2022, 1–18. [Google Scholar] [CrossRef]
- Kojima, H. Studies on the phase transition of hydrogels and aqueous solutions of thermosensitive polymers. Polym. J. 2018, 50, 411–418. [Google Scholar] [CrossRef]
- Su, G.; Zhou, T.; Liu, X.; Zhang, Y. Two-step volume phase transition mechanism of poly(N-vinylcaprolactam) hydrogel online-tracked by two-dimensional correlation spectroscopy. Phys. Chem. Chem. Phys. 2017, 19, 27221–27232. [Google Scholar] [CrossRef]
- Sheng, Y.; Xue, M.; Wang, Y.; Zhai, X.; Zhang, S.; Wang, Q.; Ma, L.; Ding, X.; Liu, X. Aggregation behavior and foam properties of the mixture of hydrocarbon and fluorocarbon surfactants with addition of nanoparticles. J. Mol. Liq. 2020, 323, 115070. [Google Scholar] [CrossRef]
- Yakoubi, S.; Kobayashi, I.; Uemura, K.; Horchani-Naifer, K.; Saidani-Tounsi, M.; Nakajima, M.; Hiroko, I.; Neves, M.A. Development of a novel colloidal system enhancing the dispersibility of tocopherol nanoparticles in a nanoscale nutraceutical delivery system. Colloids Surfaces A Physicochem. Eng. Asp. 2023, 668, 131348. [Google Scholar] [CrossRef]
- Wang, Z.-Y.; Gang, H.-Z.; He, X.-J.; Bao, X.-N.; Ye, R.-Q.; Yang, S.-Z.; Li, Y.-C.; Mu, B.-Z. The middle phenyl-group at the hydrophobic tails of bio-based zwitterionic surfactants induced waved monolayers and more hydrated status on the surface of water. Colloids Surfaces A Physicochem. Eng. Asp. 2021, 622, 126655. [Google Scholar] [CrossRef]
- Deng, J.; Yang, Y.; Tang, K. Research on preparation and fire extinguishing performance of temperature-sensitive hygrogel. J. China Univ. Min. Technol. 2014, 43, 1–7. [Google Scholar] [CrossRef]
- Lee, J.B.; Derome, D.; Guyer, R.; Carmeliet, J. Modeling the maximum spreading of liquid droplets impacting wetting and nonwetting surfaces. Langmuir 2016, 32, 1299–1308. [Google Scholar] [CrossRef]
- Chow, K.T.; Chan, L.W.; Heng, P.W. Characterization of spreadability of nonaqueous ethylcellulose gel matrices using dynamic contact angle. J. Pharm. Sci. 2008, 97, 3467–3482. [Google Scholar] [CrossRef]

| Samples | HPC Porous Systems (wt%) | HPC Systems (wt%) | Water (wt%) |
|---|---|---|---|
| P-0 | 0 | 20 | 80 |
| P-5% | 5 | 0 | 95 |
| P-10% | 10 | 0 | 90 |
| P-15% | 15 | 0 | 85 |
| P-20% | 20 | 0 | 80 |
| P-25% | 25 | 0 | 75 |
| Samples | 300 s | 600 s | ||
|---|---|---|---|---|
| Horizontal Batten | Vertical Batten | Horizontal Batten | Vertical Batten | |
| Water | 3.43% | 1.30% | 3.20% | 1.20% |
| P-0 | 36.05% | 29.05% | 28.93% | 24.95% |
| P-20% | 41.23% | 37.11% | 35.87% | 30.04% |
| Component | HPMC (wt%) | PEG (wt%) | CS (wt%) | CH3COOH (wt%) | Na2CO3 (wt%) |
|---|---|---|---|---|---|
| Concentration | 3.0 | 1.5 | 0.4 | 0.375 | 0.3 |
Disclaimer/Publisher’s Note: The statements, opinions and data contained in all publications are solely those of the individual author(s) and contributor(s) and not of MDPI and/or the editor(s). MDPI and/or the editor(s) disclaim responsibility for any injury to people or property resulting from any ideas, methods, instructions or products referred to in the content. |
© 2023 by the authors. Licensee MDPI, Basel, Switzerland. This article is an open access article distributed under the terms and conditions of the Creative Commons Attribution (CC BY) license (https://creativecommons.org/licenses/by/4.0/).
Share and Cite
Ma, L.; Shi, T.; Zhang, Z.; Liu, X.; Wang, H. Wettability of HPMC/PEG/CS Thermosensitive Porous Hydrogels. Gels 2023, 9, 667. https://doi.org/10.3390/gels9080667
Ma L, Shi T, Zhang Z, Liu X, Wang H. Wettability of HPMC/PEG/CS Thermosensitive Porous Hydrogels. Gels. 2023; 9(8):667. https://doi.org/10.3390/gels9080667
Chicago/Turabian StyleMa, Li, Tong Shi, Zhaoyun Zhang, Xixi Liu, and Hui Wang. 2023. "Wettability of HPMC/PEG/CS Thermosensitive Porous Hydrogels" Gels 9, no. 8: 667. https://doi.org/10.3390/gels9080667
APA StyleMa, L., Shi, T., Zhang, Z., Liu, X., & Wang, H. (2023). Wettability of HPMC/PEG/CS Thermosensitive Porous Hydrogels. Gels, 9(8), 667. https://doi.org/10.3390/gels9080667
